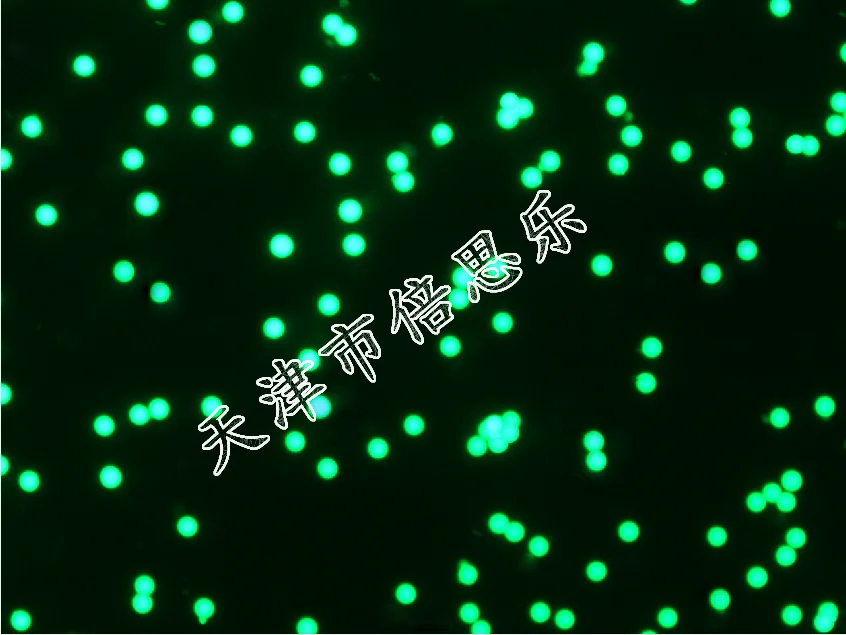

Lumisphere Monodisperse Polymethyl Methacrylate Fluorescent Microspheres/red Orange Green Blue/PMMA Fluorescent Microsphere

артикул: 1005002797148101
СОГЛАСНО НАШИМ ДАННЫМ, ЭТОТ ПРОДУКТ СЕЙЧАС НЕ ДОСТУПЕН
$116.45
Доставка из: Китай
График изменения цены & курс обмена валют
Пользователи также просматривали

$2.33
2 Pcs Massage Handball Acupoint Message Supplies Leisure Foot Massager Round Balls Stress for Adults
aliexpress.ru
$115.12
Короткая брошь Меховой шарф Свадебное болеро Свадебная шаль Вечернее платье Шаль Плечо Шаль Черный 50 x 50 белый
joom.ru
$28.96
Y2K женская плиссированная мини-юбка с кисточками винтажная повседневная джинсовая юбка с высокой талией и стежком 2000-х годов корейская модная клубная одежда
joom.ru
$4.39
Аксессуары шейный комплект ювелирных изделий с подсолнухом, сапфировые серьги, ожерелье, набор заклепок для ушей, женское ожерелье
joom.ru
$5.50
Плата конвертера DISP Преобразователь интерфейса DSI Адаптер DISP 22PIN на 15PIN для вычислительного модуля Raspberry Pi
joom.ru
$37.01
BORREY, 12 шт./лот, кубики льда из нержавеющей стали, камни для виски, винные напитки, охлаждающий камень, охладитель для пива, охладитель для льда, виски, рок-охладитель, инструмент для бара
joom.ru
$17.04
60x180 см Hololive VTuber Nakiri Ayame милая девушка двусторонняя обнимающая наволочка для тела чехол аниме длинная подушка домашнее постельное белье
joom.ru
$19.04
Стильный костюм идола, кукла, куртка на молнии, спортивная одежда для куклы, школьная форма, костюм, мини-одежда, брюки
joom.ru
$10.55
16A Вкл. Выкл. Кнопочный переключатель воздушного потока. Набор инструментов для гидромассажа. Набор трубок для спа-ванны.
joom.ru
$16.68
Свадебные аксессуары, эластичные ремни для живота, пояс со стразами, эластичный пояс, свадебный ремень на талию
joom.ru
$61.80
Комплект тату-машины, катушки для татуировки, источник питания для татуировки, иглы для татуировки, полный инструмент для татуировки
joom.ru
$2.52
Твердая текстура Десерт Ложка Гладкая поверхность Отличный Мультяшный узор Суп Помешивание Деревянный
joom.ru
$146.94
dress shoes summer walk moccasin piping woman loafers suede leather metal lock women flat slip on causal soft beanie dark blue 230224, Black
dhgate.com
$61.08
slipper woman slides beach slides sandals fashion summergirls black white red animal printsread flip floral foam
dhgate.com
$1.76
new thread long tassel earrings rhinestone drop statement fringe earrings for women luxury tear drop earrings rhinestone tassel dangle, Silver
dhgate.com
$39.16
waistbands belts women's cowhide thin belt small west decorative sweater with dress waist jeans, Black;brown
dhgate.com
$33.02
nomikuma chic lace up square collar women dresses sweet bowknot puff short sleeve vestidos femme high waist a-line dress 6g978 210427, Black;gray
dhgate.com
$365.16
stage wear don quixote ballet dress black red romantic tutu professional ballet long tutu spanish dance costume spanish kitr7850652
dhgate.com
$32.64
2021 new alyx bracelet ttitanium alloy 11 version track alyx hip hop cuff bracelets 1017 alyx 9sm 190007 q074537228, Black
dhgate.com
$38.22
hoka clifton 9 8 one running shoes hokas bondi 8 carbon 2 women men low mesh trainers triple white black people ons cloud designer sports sn
dhgate.com
$8.07
Temperature Probe Stainless Steel Temperature Sensor For Chemical Industry For Medicine
walmart.com